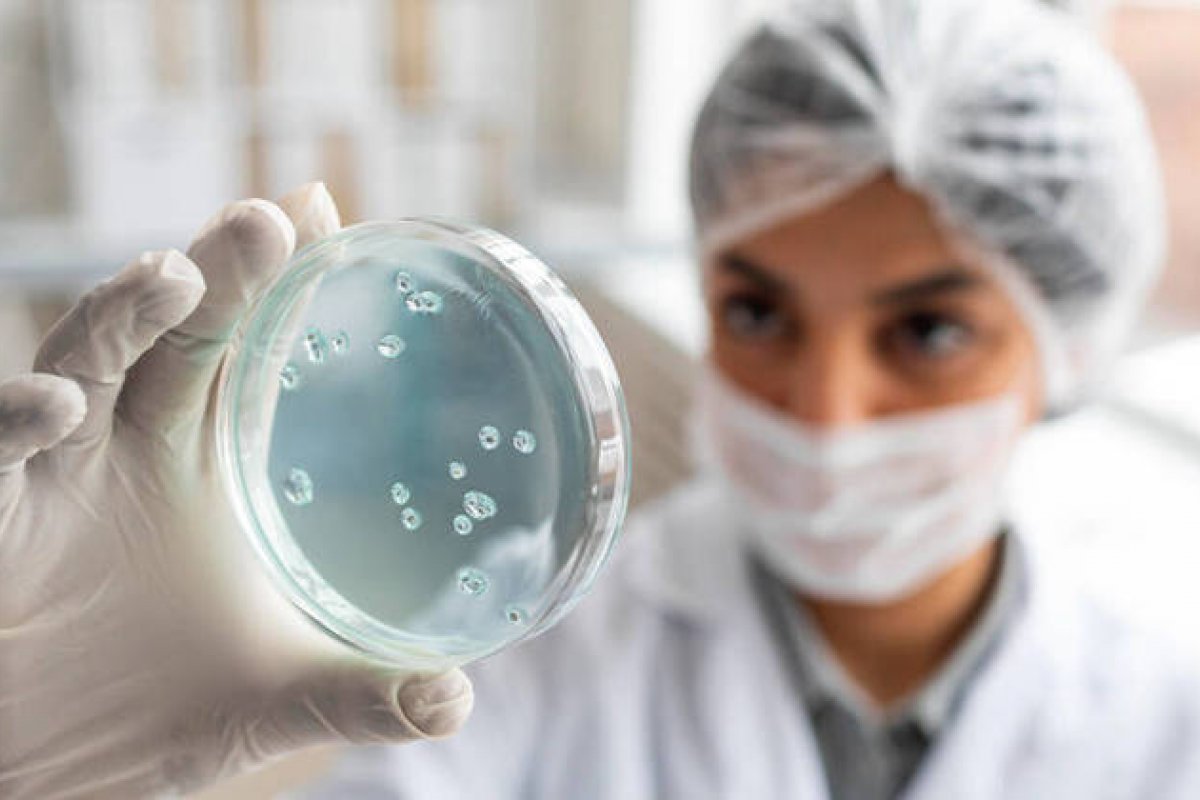
Probiótico é desenvolvido por cientistas para tratar esclerose múltipla, aponta estudo

Probiótico é desenvolvido por cientistas para tratar esclerose múltipla, aponta estudo
Bactérias foram capazes de suprimir a autoimunidade e reduzir a inflamação cerebral
Foto: Freepik
Uma pesquisa conduzida por cientistas de Brigham and Women's Hospital, ligado à Universidade de Harvard, nos Estados Unidos, apresentou descobertas que poderão ser usadas no tratamento de doenças autoimunes, como a esclerose múltipla. A abordagem envolve o uso de bactérias probióticas projetadas para suprimir a autoimunidade e reduzir a inflamação cerebral.
Os publicados na revista Nature sugerem um novo horizonte no tratamento de condições autoimunes no cérebro.
Os probióticos, já conhecidos por seus benefícios à saúde intestinal, agora estão sendo empregados de maneira inovadora. Liderados pelo imunologista e neurocientista Francisco Quintana, professor de Harvard, os pesquisadores desenvolveram bactérias probióticas geneticamente modificadas capazes de produzir compostos relevantes para o tratamento de doenças autoimunes no cérebro.
Essas bactérias agem como fábricas internas de medicamentos, proporcionando um potencial tratamento contínuo e direcionado.
Os experimentos foram realizados em camundongos com uma condição similar à esclerose múltipla mostraram resultados encorajadores.
Essas bactérias probióticas, mesmo residentes no intestino, foram capazes de enviar sinais bioquímicos benéficos ao sistema nervoso central. Apesar de o estudo atual ter se concentrado exclusivamente nos efeitos do probiótico em camundongos, os cientistas estão otimistas em relação ao uso dele na medicina.
Além disso, os pesquisadores estão empenhados em adaptar sua metodologia para tratar doenças autoimunes que acometem diferentes regiões do corpo, especialmente aquelas relacionadas ao trato intestinal, como é o caso da síndrome do intestino irritável.


